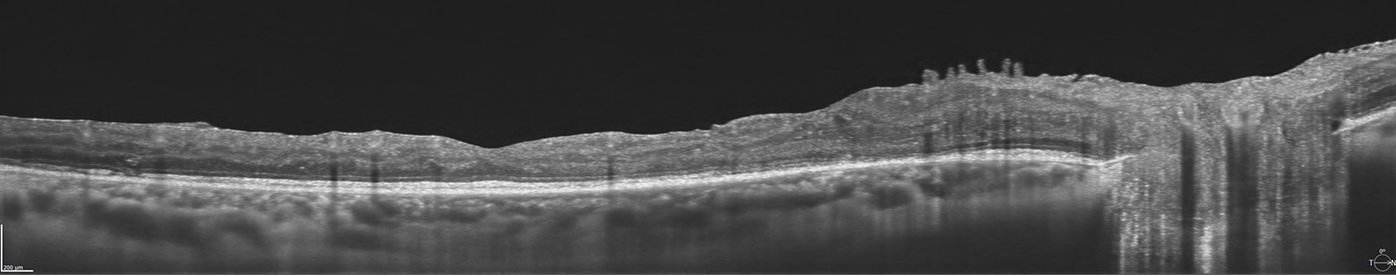

SD-OCT REVO 80
Art.Nr.: 48000020
Hersteller: Optopol
Preis auf Anfrage
Zahlungsweisen:


SD-OCT REVO 80

Das REVO 80 vereint eine beachtliche Leistung von 80.000 A-Scans pro Sekunde und 5 µm Auflösung mit einem unschlagbaren Preis-Leistungsverhältnis.
Die Firma Optopol hat im Jahr 2006 das erste SD-OCT für die Ophthalmologie auf den Markt gebracht. Kontinuierliche Weiterentwicklung, verbunden mit der Innovationskraft eines jungen und flexiblen Unternehmens, brachte die REVO SD-OCT Produktfamilie hervor.
Highlights:
- 80.000 A-Scans / Sekunde
- 5 µm Auflösung
- KI-gestützte Layer-Erkennung
- Full Range Aufnahmen
- Sehr kompakt, passt in jede Praxis
- Netzhaut - Glaukom - Vorderabschnitt - Topographie
- Biometrie und Myopie-Management (optional)
- Vollautomatische One-Touch Messung
- Voll ausgestattet, guter Preis
Das REVO 80 bietet 80.000 S-Scans pro Sekunde mit 5 µm Auflösung

- Bis zu 15 x 15 mm Scanbereich
- KI-gestüzte Layererkennung
- Automatisches Follow-up
- Normative Datenbanken für Nethautdicken und Ganglion-Komplex
- Verlaufsdarstellung von bis zu sechs Untersuchungen
- Vergleich zweier beliebiger Untersuchungen
- 3D-Darstellung mit Layer Shift


- Geometrische Auswertung des Sehnervs (Cup/Disc)
- Nervenfaserschichtanalyse (GDX)
- DDLS-Analyse
- Ganglien-Komplex-Analyse
- Automatisches Follow-up
- Normative Datenbanken für Geometrien (Cup/Disc), Nervenfasern, Ganglienzellen
- Verlaufsdarstellung von bis zu sechs Untersuchungen
Ganglienzellenanalyse

Die Ganglienzellenanalyse des REVO OCTs liefert eine zusätzliche Glaukom-Analyse neben der konventionellen papillären, retinalen Nervenfaserschichtdickenmessung. Sie können zwischen drei Analyseformen wählen: NFL+GCL+ IPL-Dicke, GCL+ IPL-Dicke, NFL-Dicke. Diese Grafiken sind zusätzlich mit der jeweiligen Normativdatenbank hinterlegt. Die Kombination von Ganglienzellenanalyse mit papillärer, retinaler Nervenfaserschichtdicke liefert einen besseren Biomarker für Ihr Glaukommanagement.
Automatische Analyse
Mit der V.21 wurde eine Funktion eingebaut, die langjährige Optopol Nutzende von den ersten OCT-Modellen vielleicht noch kennen. Der Button “Automatisch Analysieren” spart Zeit und beschleunigt die Praxisabläufe. Sobald alle Messungen durchgeführt wurden und der Patient zum Warten oder ins Arztzimmer gebeten wird, kann auf “Automatisch Analysieren” geklickt werden und die Scans werden im Hintergrund analysiert. Sobald der Arzt oder die Ärztin die OCT-Aufnahmen sehen möchte, werden diese ohne Warte-/Analysezeit aufgerufen.
Katarakt Modus
Der neu eingeführte Katarakt Modus erlaubt detailreiche OCT-Scans trotz getrübter Medien. Die Scan-Geschwindigkeit kann bewusst reduziert werden, um eine höhere Eindringtiefe zu erreichen und die Sättigung der OCT-Scans zu erhöhen*.



- 18 mm Scan-Breite
- Darstellung des vollständigen vorderen Systems
- Messung beider Kammerwinkel in einer Aufnahme
- Automatische Pachymetrie
- Analyse des Kammerwinkels
- Darstellung der Iris


Vollautomatische 10-fach Messung:
- AL: Achslänge
- ACD: Vorderkammertiefe
- LT: Linsendicke
- CCT: Hornhautdicke
Zusätzlich existiert ein Scanprogramm zur detaillierten Darstellung der Vorderkammer.


Das OCT-Topographie-Modul (OCT-T) ermöglicht eine umfangreiche Analyse der beiden Grenzflächen der Hornhaut. Zu den wichtigsten Analysen gehören die Ermittlung der Krümmungsradien (K1 und K2) der Hornhaut sowie die daraus resultierende Brechkraft der Hornhaut. Die Werte vervollständigen das in Version 8.0 veröffentlichte OCT-Biometrie-Modul (OCT-B) der Copernicus REVO Reihe. Für die Auswertung der Ergebnisse stehen eine Vielzahl unterschiedlichster Darstellungen zur Verfügung. Die OCT-T-Technologie basiert auf dem Prinzip des Ray Tracings. Dabei wird neben der Vorder- und Rückfläche der Hornhaut auch die korrespondierende Hornhautdicke ermittelt
Konnektivität / Netzwerk:
- Kostenlose Server- und Viewer Programme (Installationsservice)
- Viewer dürfen an verbundene Praxen weiter gegeben werden
- Standortvernetzung
- Diverse Schnittstellen zu Ihrer Verwaltungssoftware
- DICOM
- Automatischer Export
Technische Daten:
- Technologie: Spectral Domain OCT
- Messmodi: B-Scan, Radial-Scan, Raster, Cross, 3D, Raster-Scan, Multiline-Scan, Gefäß-Scan
- Messmethode: Vollautomatisch
- Fundusdarstellung: pSLO (Live Fundus Rekonstruktion)
- Fixation: OLED Bildschirm (Fovea u. Disk) - variable Position und Form, externe Fixation
- Wellenlänge: 830 nm
- Axiale Auflösung: 5 µm (optisch) im Gewebe und 2,8 µm (digital)
- horiz. Auflösung: 12-18 µm
- Axiale Scantiefe: min. 2 mm
- Geschwindigkeit: 80.000 A-Scans / s
- Scan-Breiten: posterior 5 bis 15 mm, anterior 3 bis 18 mm
- Max. Fläche 3D Scan: 15 x 15 mm
- Min. Pupille: 2,4 mm
Analyse-Software:
Retina Analyse:
- Retina-Dicke
- RNFL+ GCL+IPL-Dicke (Nervenfaserschicht-, Ganglienzellschicht-, Innere Plexifromeschicht-Dicke)
- GCL+IPL-Dicke
- RNFL-Dicke
- RPE Deformationskarte
- IS/OS Dicke
- Follow-up
Glaukom:
- Nervenfaserschichtdicke
- ONH Morphologie
- DDLS - Disc Damage Likelyhood Scale
- Ganglienzellanalyse mit Asymmetrievergleich
- Follow-up
Anterior:
- Pachymetrie
- LASIK Flap Vermessung
- Kammerwinkelmessung
- Weitwinkel-Scans
- REVO 80 OCT
- Viewer und Server Applikationen
- Anterior Wide Field
Optional erhältlich:
- HP All-In-One Profi-PC mit Multitouch Display
- Tischpaket
- OCT-T: Topographie-Modul
- Biometrie-Modul
- Myopie-Management




